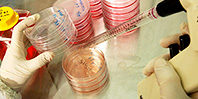

Ученые создали уникальные имплантаты для пересадки костного мозга

Команда специалистов из США разработала биометрическую костную ткань для пациентов, нуждающихся в трансплантации костного мозга. В ней может созревать костный мозг. Благодаря такому имплантату процедура пересадки станет безопаснее. К сожалению, людям с раком костного мозга имплантат не поможет.
Перед трансплантацией пациент обычно получает дозу радиации (иногда в сочетании с лекарствами) для уничтожения стволовых клеток в костном мозге. Благодаря этому донорские клетки выживают и развиваются, не конкурируя с клетками пациента. Однако такое лечение часто сопровождается рядом побочных эффектов, таких как тошнота, усталость, снижение фертильности.
Новая костная ткань позволяет донорским клеткам развиваться без конкуренции. При этом нет необходимости в уничтожении клеток пациента. По своей структуре имплантаты похожи на длинные трубчатые кости. Они состоят из внешнего и внутреннего отсеков. Имплантаты сделаны из пористого гидрогеля.
Ученые провели исследование на мышах. Они заметили, что имплантаты становились частью костной ткани грызунов. В них была рабочая сеть кровеносных сосудов и созревал костный мозг, способный производить новые клетки крови. Спустя 4 недели исследователи обнаружили в костном мозге донорские клетки и клетки реципиента. Эти клетки циркулировали в крови мышей даже 24 недели спустя.
материал с сайта www.med2.ru